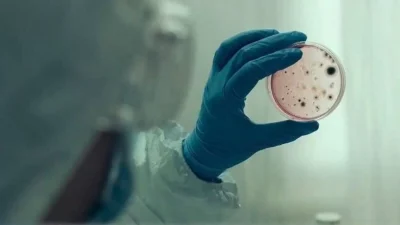
Παραλλαγή Κένταυρος: "Επέλαση" του ιού από το φθινόπωρο και μετά - Ο Σαριγιάννης προειδοποιεί

Συναγερμός για τις πυρόπληκτες περιοχές και όχι μόνο σήμανε ο Σάκης Αρναούτογλου. Ο μετεωρολόγος με ανάρτησή του στον λογαριασμό του στο Facebook προειδοποίησε τον κόσμο πως υπάρχει κίνδυνος για τους ανέμους που συνοδεύουν τις καταιγίδες οι οποίες πλήττουν πολλές περιοχές της Ελλάδος.
Aναλυτικά η ανάρτηση του Σάκη Αρναούτογλου για τον καιρό
«Φίλες και φίλοι! Και τα τελευταία προγνωστικά στοιχεία θέλουν αρκετές περιοχές της χώρας (στεριά, ακόμα και νησιά και κυρίως οι Σποράδες, η Αττική αλλά δυστυχώς και οι πυρόπληκτες περιοχές) να δέχονται έντονα καιρικά φαινόμενα κι αυτό κατά διαστήματα (όχι όλη την ημέρα) από σήμερα και μέχρι την ερχόμενη Πέμπτη, ίσως και πιο τοπικά και την Παρασκευή!
Με αυτά τα δεδομένα, πέρα από τα αιφνίδια πλημμυρικά φαινόμενα, κίνδυνος υπάρχει και από τους ανέμους που συνήθως συνοδεύουν τις καταιγίδες, ενώ δεν αποκλείεται οι συνθήκες να είναι ευνοϊκές ακόμα και για το σχηματισμό σιφώνων! Σε κάθε περίπτωση και για καλό και για κακό, κατά την ταπεινή μου άποψη θεωρώ πως είναι αναγκαία η επαγρύπνηση αλλά και η λήψη στοιχειωδών μέτρων προφύλαξης!
Ραντεβού για λεπτομέρειες στο δελτίο καιρού της ΕΡΤ3, που θα μεταδίδεται προς το παρόν καθημερινά στις 16:30!
Με εκτίμηση».

Η πρόγνωση του καιρού για σήμερα 22/8
ΜΑΚΕΔΟΝΙΑ, ΘΡΑΚΗ
Καιρός: Κατά διαστήματα αυξημένες νεφώσεις με τοπικές βροχές και καταιγίδες. Τα φαινόμενα τις μεσημβρινές και απογευματινές ώρες πιθανόν πρόσκαιρα να είναι ισχυρά στη Μακεδονία. Το βράδυ αναμένεται βελτίωση στη δυτική Μακεδονία.
Ανεμοι: Από βόρειες διευθύνσεις 3 με 4 μποφόρ.
Θερμοκρασία: Από 19 έως 31 βαθμούς και στα δυτική Μακεδονία 2 με 3 βαθμούς χαμηλότερη.
ΝΗΣΙΑ ΙΟΝΙΟΥ, ΗΠΕΙΡΟΣ, ΔΥΤΙΚΗ ΣΤΕΡΕΑ, ΔΥΤΙΚΗ ΠΕΛΟΠΟΝΝΗΣΟΣ
Καιρός: Λίγες νεφώσεις που βαθμιαία στα ηπειρωτικά θα αυξηθούν και θα σημειωθούν στα ορεινά της Ηπείρου και της δυτικής Στερεάς τις μεσημβρινές και απογευματινές ώρες μεμονωμένες καταιγίδες.
Ανεμοι: Βορειοδυτικοί 3 με 4 και στο Ιόνιο τοπικά 5 μποφόρ.
Θερμοκρασία: Από 22 έως 33 βαθμούς Κελσίου. Στο εσωτερικό της Ηπείρου 2 με 3 βαθμούς χαμηλότερη.
ΘΕΣΣΑΛΙΑ, ΑΝΑΤΟΛΙΚΗ ΣΤΕΡΕΑ, ΑΝΑΤΟΛΙΚΗ ΠΕΛΟΠΟΝΝΗΣΟΣ
Καιρός: Λίγες νεφώσεις που βαθμιαία θα αυξηθούν και θα σημειωθούν τοπικές βροχές και καταιγίδες αρχικά στη Θεσσαλία, τις Σποράδες, την Εύβοια και τις μεσημβρινές απογευματινές ώρες στην ανατολική Στερεά και την ανατολική Πελοπόννησο. Το βράδυ τα φαινόμενα θα σταματήσουν.
Ανεμοι: Μεταβλητοί 3 με 4 και στα νότια δυτικοί έως 5 μποφόρ.
Θερμοκρασία: Από 23 έως 33 βαθμούς Κελσίου.
ΚΥΚΛΑΔΕΣ, ΚΡΗΤΗ
Καιρός: Λίγες νεφώσεις οι οποίες στην Κρήτη τις μεσημβρινές απογευματινές ώρες θα αυξηθούν και θα σημειωθούν στα ορεινά τοπικοί όμβροι.
Ανεμοι: Δυτικοί βορειοδυτικοί 3 με 4 μποφόρ και στην Κρήτη τοπικά 5 μποφόρ.
Θερμοκρασία: Από 24 έως 31 βαθμούς Κελσίου.
ΝΗΣΙΑ ΑΝΑΤΟΛΙΚΟΥ ΑΙΓΑΙΟΥ – ΔΩΔΕΚΑΝΗΣΑ
Καιρός: Γενικά αίθριος. Στα βόρεια πρόσκαιρες τοπικές νεφώσεις.
Ανεμοι: Βόρειοι βορειοδυτικοί 3 με 5 και στα νότια δυτικοί 3 με 4 μποφόρ.
Θερμοκρασία: Από 24 έως 31 βαθμούς Κελσίου.
ΕΥΒΟΙΑ
Καιρός: Λίγες νεφώσεις που βαθμιαία θα αυξηθούν και θα σημειωθούν τοπικές βροχές και καταιγίδες. Το βράδυ τα φαινόμενα θα σταματήσουν.
Ανεμοι: Βόρειοι 3 με 4 μποφόρ.
Θερμοκρασία: Από 23 έως 34 βαθμούς Κελσίου.
ΑΤΤΙΚΗ
Καιρός: Λίγες νεφώσεις που βαθμιαία θα αυξηθούν και τις μεσημβρινές και απογευματινές ώρες θα σημειωθούν τοπικοί όμβροι ή μεμονωμένες καταιγίδες.
Ανεμοι: Μεταβλητοί 2 με 4 μποφόρ.
Θερμοκρασία: Από 23 έως 33 βαθμούς Κελσίου.
ΘΕΣΣΑΛΟΝΙΚΗ
Καιρός: Κατά διαστήματα αυξημένες νεφώσεις με τοπικές βροχές και καταιγίδες κυρίως τις μεσημβρινές απογευματινές ώρες.
Ανεμοι: Μεταβλητοί 2 με 4 μποφόρ.
Θερμοκρασία: Από 21 έως 29 βαθμούς Κελσίου.

">
"> ">
"> ">
"> ">
"> ">
"> ">
"> ">
">